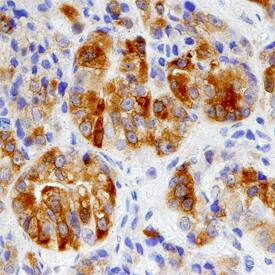
Cytosolic Sulfotransferase 2B1/SULT2B1 antibody in Human Prostate Cancer Tissue by Immunohistochemistry (IHC-P).

Human Cytosolic Sulfotransferase 2B1/SULT2B1 Antibody
R&D Systems, part of Bio-Techne | Catalog # AF6174


Key Product Details
Species Reactivity
Validated:
Cited:
Applications
Validated:
Cited:
Label
Antibody Source
Product Specifications
Immunogen
Asp2-Ser365
Accession # O00204
Specificity
Clonality
Host
Isotype
Scientific Data Images for Human Cytosolic Sulfotransferase 2B1/SULT2B1 Antibody
Detection of Human Cytosolic Sulfotransferase 2B1/SULT2B1 by Western Blot.
Western blot shows lysates of human prostate cancer tissue. PVDF Membrane was probed with 1 µg/mL of Human Cytosolic Sulfotransferase 2B1/SULT2B1 Antigen Affinity-purified Polyclonal Antibody (Catalog # AF6174) followed by HRP-conjugated Anti-Sheep IgG Secondary Antibody (Catalog # HAF016). A specific band was detected for Cytosolic Sulfotransferase 2B1/SULT2B1 at approximately 48 kDa (as indicated). This experiment was conducted under reducing conditions and using Immunoblot Buffer Group 8.Cytosolic Sulfotransferase 2B1/SULT2B1 in Human Prostate Cancer Tissue.
Cytosolic Sulfotransferase 2B1/SULT2B1 was detected in immersion fixed paraffin-embedded sections of human prostate cancer tissue using Human Cytosolic Sulfotransferase 2B1/SULT2B1 Antigen Affinity-purified Polyclonal Antibody (Catalog # AF6174) at 3 µg/mL overnight at 4 °C. Before incubation with the primary antibody, tissue was subjected to heat-induced epitope retrieval using Antigen Retrieval Reagent-Basic (Catalog # CTS013). Tissue was stained using the Anti-Sheep HRP-DAB Cell & Tissue Staining Kit (brown; Catalog # CTS019) and counterstained with hematoxylin (blue). Specific staining was localized to the cytoplasm of glandular epithelial and stromal cells. View our protocol for Chromogenic IHC Staining of Paraffin-embedded Tissue Sections.Applications for Human Cytosolic Sulfotransferase 2B1/SULT2B1 Antibody
Immunohistochemistry
Sample: Immersion fixed paraffin-embedded sections of human prostate cancer tissue
Immunoprecipitation
Sample: Cell lysates spiked with Recombinant Human Cytosolic Sulfotransferase 2B1/SULT2B1, see our available Western blot detection antibodies
Western Blot
Sample: Human prostate cancer tissue
Formulation, Preparation, and Storage
Purification
Reconstitution
Formulation
Shipping
Stability & Storage
- 12 months from date of receipt, -20 to -70 °C as supplied.
- 1 month, 2 to 8 °C under sterile conditions after reconstitution.
- 6 months, -20 to -70 °C under sterile conditions after reconstitution.
Background: Cytosolic Sulfotransferase 2B1/SULT2B1
SULT2B1 (Sulfotransferase 2B1; also ST2B1b and alcohol sulfotransferase) is a 45-48 kDa member of the sulfotransferase 1 family of enzymes. SULT2B1 is widely expressed, being found in platelets, stratum granulosum keratinocytes, breast and prostatic epithelium, and syncytiotrophoblast cells. SULT2B1 catalyzes the sulfonation of DHEA, a precursor for sex steroids, and cholesterol, which supports stratification of the epidermis. Human SULT2B1 is 365 amino acids (aa) in length. There are PAPS binding sites between aa 70-75 and 147-155, a myristoylation motif between aa 255-259, and a Pro-rich region between aa 305-364 that may extend enzyme half-life. There is one 43 kDa splice form (ST2B1a) that shows an eight aa substitution for aa 1-23. It is expressed in fetal brain and generates pregnenolone sulfate, a steroid that modulates neurotransmitters. Full-length human SULT2B1b shares only 71% aa identity with mouse SULT2B1.
Alternate Names
Gene Symbol
UniProt
Additional Cytosolic Sulfotransferase 2B1/SULT2B1 Products
Product Documents for Human Cytosolic Sulfotransferase 2B1/SULT2B1 Antibody
Product Specific Notices for Human Cytosolic Sulfotransferase 2B1/SULT2B1 Antibody
For research use only